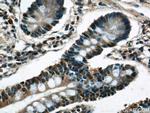
C22orf41 Antibody in Immunohistochemistry (Paraffin) (IHC (P))

Search
Proteintech
C22orf41 Polyclonal Antibody
{{$productOrderCtrl.translations['antibody.pdp.commerceCard.promotion.promotions']}}
{{$productOrderCtrl.translations['antibody.pdp.commerceCard.promotion.viewpromo']}}
{{$productOrderCtrl.translations['antibody.pdp.commerceCard.promotion.promocode']}}: {{promo.promoCode}} {{promo.promoTitle}} {{promo.promoDescription}}. {{$productOrderCtrl.translations['antibody.pdp.commerceCard.promotion.learnmore']}}
产品信息
24867-1-AP
种属反应
宿主/亚型
分类
类型
抗原
偶联物
形式
浓度
纯化类型
保存液
内含物
保存条件
运输条件
产品详细信息
Immunogen sequence: MDDADPEER NYDNMLKMLS DLNKDLEKLL EEMEKISVQA TWMAYDMVVM RTNPTLAESM RRLEDAFVNC KEEMEKNWQE LLHETKQRL (1-88 aa encoded by BC127859)
靶标信息
Major component of the transverse central element of synaptonemal complexes (SCS), formed between homologous chromosomes during meiotic prophase. Required for chromosome loading of the central element-specific SCS proteins, and for initiating synapsis between homologous chromosomes. Chromosome loading appears to require SYCP1. Required for fertility.
仅用于科研。不用于诊断过程。未经明确授权不得转售。
生物信息学
蛋白别名: Synaptonemal complex central element protein 3; Testis highly expressed gene 2 protein; testis highly expressed protein 2; Testis-specific expressed protein 2; THEG-2; TSEG-2
基因别名: 1700007E06Rik; C22orf41; SYCE3; THEG2; TSEG-2; TSEG2
UniProt ID: (Human) A1L190, (Mouse) B5KM66
Entrez Gene ID: (Human) 644186, (Mouse) 75459